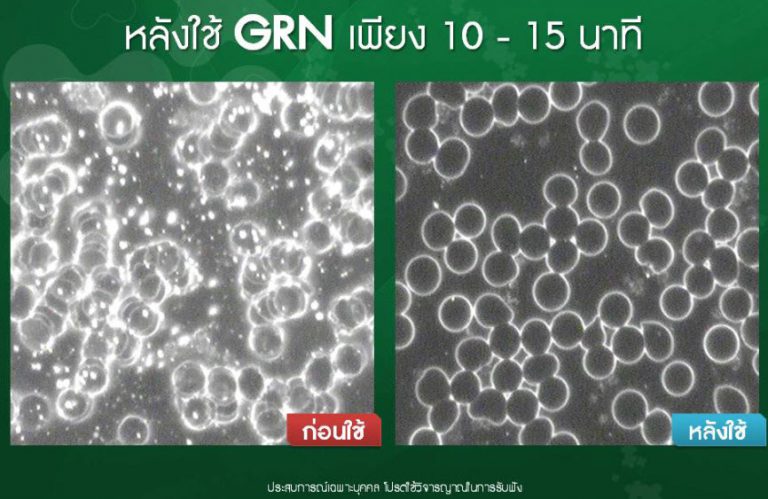

GRN ดีท๊อก ล้างเลือด ล้างลำไส้

Gel Plus GRN – เอเจล จีอาร์เอ็น กรีน
Gel Plus GRN นวัตกรรมใหม่แห่งการ ดีท็อกซ์
>>กลิ่นตะไคร้ มินต์
Detox ย่อมาจาก คำว่า Detoxification
หมาย ถึง กระบวนการในการล้างสารพิษ (Toxin) ออกจากร่างกายด้วยวิธีการต่างๆ
ซึ่งในบางกลุ่มที่ดูแลสุขภาพ อาจจะทำการทำความสะอาดลำไส้ใหญ่
หรือ Detox โดยการล้างลำไส้ ด้วยวิธีการสวน กาแฟ ผ่านทางทวารหนัก ซึ่งเป็นวิธีการที่มีความยุ่งยาก
แต่ Gel Plus GRN คือ วิธีการ ดีท็อกซ์ Detox โดยการทาน แค่เด็ดและดูด สะดวก อร่อย ทุกที่ ทำได้ทุกเวลา และทำได้ทุกวัน

Gel Plus GRN เจล พลัส จีอาร์เอ็น กรีน
ดีท็อกซ์ Detox ล้างสารพิษ ล้างลำไส้ เห็นผล
“ผลลัพธ์ในภาพและวีดิโอเป็นประสบการณ์เฉพาะบุคคล… ผลลัพธ์การช่วยเรื่องสุขภาพของแต่ละคนอาจแตกต่างกัน”
“ผลลัพธ์ในภาพและวีดิโอเป็นประสบการณ์เฉพาะบุคคล… ผลลัพธ์การช่วยเรื่องสุขภาพของแต่ละคนอาจแตกต่างกัน”
VDO เคสพิเศษ
เคสพี่หมิงเชียงราย ในวัย 40 ปลายๆ สุขภาพแย่หลายด้านโดยไม่รู้สาเหตุ
ประสบการณ์หัวใจอ่อนแรงเฉียดตาย ต้องลาตายกับสามีทุกๆ คืน รักษากับหมอเก่งๆ ก็ไม่หาย แต่กลับมาสุขภาพดีด้วย Gel แค่ 15 วันใช้เจลหลายสี UMI HRT EXO GRN FLX เพราะสุขภาพที่ดีสำคัญมาก
“ผลลัพธ์ในภาพและวีดิโอเป็นประสบการณ์เฉพาะบุคคล… ผลลัพธ์การช่วยเรื่องสุขภาพของแต่ละคนอาจแตกต่างกัน”
Gel PLus GRN นวัตกรรมใหม่แห่งการ ดีท็อกซ์ Detox
กลิ่นตะไคร้ มินต์ Detox
ย่อมาจาก คำว่า Detoxification หมาย ถึง กระบวนการในการล้างสารพิษ (Toxin) ออกจากร่างกายด้วยวิธีการต่างๆ
ซึ่งในบางกลุ่มที่ดูแลสุขภาพ อาจจะทำการทำความสะอาดลำไส้ใหญ่ หรือ Detox
โดยการล้างลำไส้ ด้วยวิธีการสวน กาแฟ ผ่านทางทวารหนัก ซึ่งเป็นวิธีการที่มีความยุ่งยาก
แต่ Gel PLus GRN คือ วิธีการ ดีท็อกซ์ Detox โดยการทาน สะดวก อร่อย และทำได้ทุกวัน

“ผลลัพธ์ในภาพและวีดิโอเป็นประสบการณ์เฉพาะบุคคล… ผลลัพธ์การช่วยเรื่องสุขภาพของแต่ละคนอาจแตกต่างกัน”

ประโยชน์ของพืชสีเขียว (Greens)
- ให้พลังงานจากสารอาหารธรรมชาติ ปราศจากสารกระตุ้น
- ลดความอยากอาหาร ช่วยระบบเผาผลาญไขมันและควบคุมน้ำหนัก
- ช่วยระบบย่อยอาหารและระบบขับถ่าย ขับสารพิษ
- บรรเทาอาการอักเสบ และ บรรเทาอาการปวดของเอ็นและกล้ามเนื้อ
- ลดการอุดตันในหลอดเลือด
- ช่วยระบบภูมิคุ้มกัน และ ช่วยเพิ่มสารต้านอนุมูลอิสระ
- ลดอาการแพ้
- ช่วยให้มีสมาธิ
- ล้างสารพิษ ดีท็อกซ์ Detox
- ช่วยให้ผิวหนังและเส้นผมมีสุขภาพดี แลดูอ่อนเยาว์
ส่วนประกอบสำคัญของ Gel Plus GRN
คือ สุดยอดพืชและสาหร่าย อุดมไปด้วยคลอโลฟิลลสีเขียว 9ชนิด
- สาหร่ายสไปรูไลนา Spirulina Algae
- สาหร่ายคลอเรลลา Chlorella Vulgaris
- ผักปวยเล้ง ผักโขม Spinach
- อัลฟาฟ่า Alfalfa Herb
- ข้าวบาร์เลย์อ่อน Barley Grass
- บรอคโคลี่ Broccoli
- Spearmint leaf
- ใบสะระแหน่ Pepermint leaf
- ต้นข้าวสาลีอ่อน Wheat grass
คอปเปอร์ คลอโรฟิลลิน
- ช่วยระบบย่อยอาหาร และการขับถ่าย
- ล้างสารพิษ ดีท็อกซ์ Detox และทำความสะอาดระบบทางเดินอาหาร
- สนับสนุนให้แบคทีเรียที่มีอยู่ในระบบทางเดินอาหารทำงานได้ดีขึ้o
นักวิทยาศาสตร์ค้นพบว่า การสะสมพิษ เช่น อุจจาระตกค้าง ตะกรัน(Chronic dunk) ที่ลำไส้ใหญ่ หรือ อาการท้องผูก เป็นสาเหตุหลักที่ทำให้ร่างกายเราอ่อนแอและเกิดโรคต่าง ๆ ตามมาได้ง่าย เนื่องจากลำไส้เป็นอวัยวะที่ร่างกายเราไม่สามารถมองเห็นได้ จึงถูกละเลยในการดูแล

ประโยชน์ของการเคล็นส์เซอร์ (Cleanser) (การชะล้างสารพิษ)
- ล้างสารพิษที่สะสมในร่างกาย
- ล้างสารโลหะหนักที่เป็นอันตราย เช่น ปรอท และ ตะกั่ว
ล้างสารพิษในตับ - ช่วยดูแลแบคที่เรียที่เป็นประโยชน์
- ช่วยระบบภูมิคุ้มกัน
วิธีรับประทานครั้งละ 1 ซอง วันละ 1 ครั้ง หลังอาหาร

* These statements have not been evaluated by the Food and Drug Administration. This product is not intended to diagnose, treat, cure or prevent any disease.
“ผลิตภัณฑ์ Gel PLus เจล พลัส Agel อาเจล เป็นผลิตภัณฑ์สำหรับเสริมอาหาร ไม่มีผลในการป้องกันหรือรักษาโรค, ควรกินอาหารหลากหลายครบทั้ง 5 หมู่ในสัดส่วนที่เหมาะสมเป็นประจำ”






